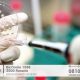
Tratan con células madre a nena con labio leporino

Beneficios del pilates para las embarazadas
Esta actividad combina la flexibilidad y la fuerza, pero no requiere movimientos bruscos. Por esta razón su práctica es muy común entre embarazadas. Además, refuerza la musculatura de la pelvis y la zona abdominal, algo ideal para mujeres en este estado.
De esta forma, ayuda a aliviar las molestias físicas del embarazo, además de aportarnos otros beneficios. Por ejemplo, al fortalecer la pared abdominal, nos será más fácil ejercer presión durante el parto.
Además, con el pilates reducimos la tensión en los músculos de esta zona y la intensidad de la curva lumbar. Por otra parte, también estimula la circulación sanguínea de las piernas, lo que resulta realmente beneficioso durante el período de gestación.
También nos ayuda a mejorar el funcionamiento del sistema cardiovascular, disminuyendo con ello la aparición de varices. Mejora la tensión arterial, además de ayudar a reducir la celulitis, la retención de líquidos y los calambres musculares. Sin olvidar que estos ejercicios favorecen el buen funcionamiento del sistema digestivo (reduciendo el estreñimiento y los gases) y que tienen propiedades beneficiosas para nuestro estado psicológico. También se recomienda su práctica durante los meses posteriores al parto.
Ejercicios de pilates recomendados a embarazadas
Existen ejercicios de Pilates especialmente recomendados para futuras madres. A continuación describimos algunos de ellos.
• Apoyamos las rodillas y las manos en el suelo, con la espalda recta. Inspiramos mientras contraemos los músculos pélvicos, llevando el ombligo hacia dentro y en posición ascendente. Mantenemos esta postura durante 10 segundos, aguantando la respiración, para después soltar el aire lentamente. Repetimos el ejercicio 10 veces.
• Nos tumbamos de lado, con la pierna que queda abajo doblada y el correspondiente brazo extendido hacia arriba. Exhalamos lentamente, levantando al mismo tiempo el otro brazo y la otra pierna. Después los bajamos despacio mientras inhalamos, y hacemos de dos a cuatro repeticiones a cada lado.
• De pie, con las piernas abiertas a la altura de las caderas, nos agachamos un poco y apoyamos las manos suavemente sobre los muslos. En esta postura, inhalamos mientras arqueamos la espalda hacia adentro, haciendo el movimiento contrario mientras exhalamos, hasta curvar la espalda hacia afuera. Repetimos cuatro veces.
En cuanto a sus contraindicaciones, lo cierto es que la mayoría de las mujeres embarazadas pueden hacer Pilates, salvo en casos de hipertensión, abortos habituales, neumopatías agudas, diabetes, retraso del crecimiento intrauterino, anemia, diástasis abdominal, obesidad, enfermedades pulmonares o sangrado, entre otros. De todas formas, si jamás lo hemos practicado, no debemos comenzar antes de los tres primeros meses de gestación.
Es el médico quien tiene que evaluar si realmente podemos realizar estos ejercicios. Él sabrá decirnos si es conveniente o no para el desarrollo del embarazo y nos informará bien sobre los beneficios y posibles riesgos que conlleva el pilates para embarazadas.
fuente: http://www.cosasdebebes.com/pilates-para-embarazadas-ejercicios-recomendaciones-y-contraindicaciones/